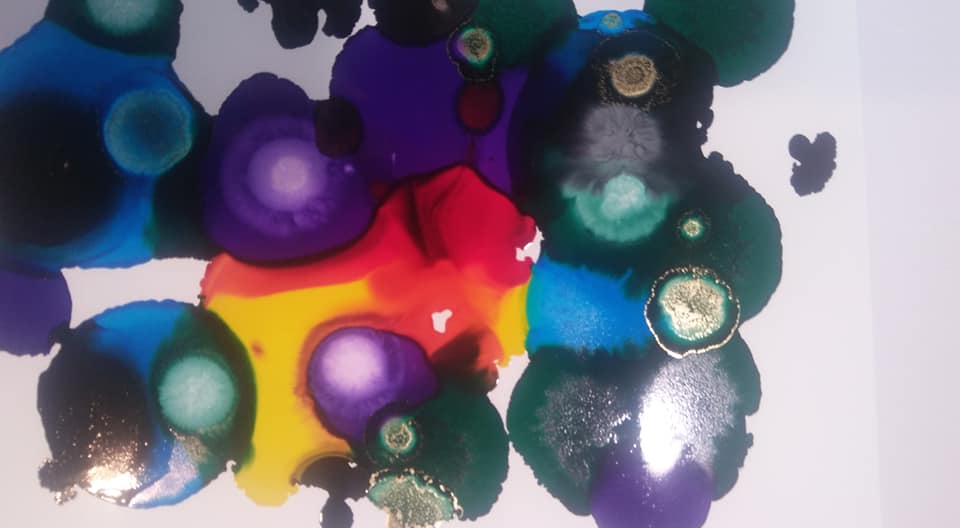

With Inktober rapidly approaching, and with my Cheeky Monkey Mind begging to do something with alcohol inks, I figured it was time to get them out and give them a try. I’ll cut right to the chase here: Playing with alcohol ink is really a lot of fun.
Of course, my initial efforts didn’t produce any gorgeous works of art. Today’s adventure was merely a way of getting acquainted with the basic properties of alcohol ink. I have lots to learn, and I’ll probably be sharing more information as I try new things.
First, I gathered up my supplies.

Next, I cut a sheet of Yupo paper in half.

Now it was time for a little fun. I was excited to open my “starter set” of alcohol inks, and I was even more excited to see information on various ways to use the inks.


The real excitement began when, drop by drop, I saw the beautiful, vibrant colors of these inks on my Yupo paper.
The inks did not spread as fast or as far as I’d expected. I used no alcohol or blending solution here. I started with orange, added red, yellow, blue, green, violet, plus drops of white, black, and gold.
Here’s a closer look at the page:
Sorry for the poor photographs.
At this point, of course I got curious, wondering what would happen if I tried different things. So, I grabbed a little alcohol straight from the bottle and poured it on. Oops! Too much, too wet, and sure enough I started getting lots of muddy colors as I attempted to swirl it all around.
Not to be deterred, however, I shrugged, carried the paper to my big studio sink, and ran it under the water. Here’s the effect it created:

No longer the bright, bold colors, but interesting all the same. I can easily imagine using something like this in my art journal.
While this little experiment was drying, I used the second half of my Yupo paper to create this little floral design:

This was done by first brushing alcohol over the entire page. Again, I was surprised that the ink didn’t flow as freely as I’d expected. I left my initial drops of ink in the center, made more drops around the page, and then used a Q-tip to move the ink around, playing with it a bit to see how much “drawing” I might be able to do. Oh, I also used my “ink blending tool” although it didn’t do a lot.
At this point, I have yet to figure out what the “alcohol blending solution” is used for or exactly how to use the blending tool. I’m planning to watch a few videos, try a few new things, and learn a bit more about these colorful inks.
I do like the colors, and I’m very pleased with the set I purchased. All primaries, secondaries, black, white, and a gold metallic. That’s more than enough to make a good start.
Yes, I think I will be using these during Inktober. I’m not sure exactly how I’ll be using them, but I’m looking forward to learning more about alcohol inks.
NOTE: You’ll find links to the products I purchased here.
.





Thank you for sharing about your experiment with alcohol ink. Looks interesting. I don’t know anything about it something else for me to learn. Have fun with further experiments.
LikeLiked by 1 person
I am having a lot of fun with my new inks. You’ll be seeing more “adventures” soon!
LikeLike
This yet to try..let us know how you went ahead with it
LikeLiked by 1 person
I’m having fun with it… lots to learn about alcohol inks! I do love the colors.
LikeLiked by 1 person
I have thought about playing with inks, but have decided to start with Copic Ciao markers.
I am eager to see how you progress with the inks and in your learning and sharing with us 💕
LikeLiked by 1 person
Have fun! I’m enjoying my alcohol inks even though I don’t know much about them yet. I want to learn different ways to use them, and I really want to incorporate them into my “Inktober” drawings this year.
LikeLiked by 1 person
Ooh, I love alcohol inks, it looks like you have some great colors to play with, enjoy!
LikeLiked by 1 person
I’m having lots of fun! I’m so glad I bought these inks. 🙂
LikeLike
Good luck with your adventures in alcohol ink! I think it’d be wonderful if you compare what you produce at the end of Inktober to your experiment to see how far you’ve come with the medium!
LikeLiked by 1 person
Oh, yes, I’m sure it will be interesting!
LikeLike
Hey great article, check out my page as I’m working with the National trust on a creative project, any feedback would be greatly appreciated. 🙂
LikeLiked by 1 person
I had a little trouble finding your blog. At first my search engine was pulling up a page that no longer exists. You might want to check that out and be sure links are going to the right place. Once I found the site, I was really awed by what I saw. I will be following along and watching your Dunescape Project. I find what you do fascinating. Thanks for sharing your site with me.
LikeLiked by 1 person
Thank you for taking the time to long Judith, how odd, I’ll have a look at that, only just started the blog so still learning the ropes 🙂
LikeLiked by 1 person
I probably clicked the wrong thing. I do that a lot. I love what you’re doing, and I’ve followed the Facebook page too.
LikeLike